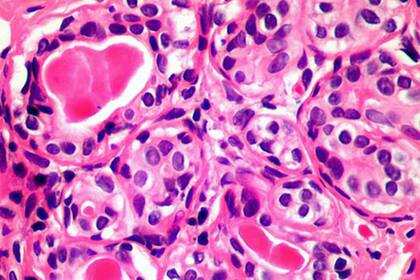
El primer control debe realizarse a los 50 años pero esto es así necesariamente si la persona no registra antecedentes de ningún tipo de cáncer en la familia

Cáncer de próstata: la prevención es el mejor aliado
Noviembre es el mes de la concientización del cáncer de próstata, una patología que padece 1 de cada 10 hombres. El control periódico y un pronto diagnóstico son claves para un mejor tratamiento
4 minutos de lectura'

El cáncer de próstata es el segundo cáncer más frecuente en hombres, afecta a 1 de cada diez y suma un total 1.3 millones de personas en el mundo. Uno de cada cuarenta morirá por este tipo de patología que es totalmente prevenible.
En este sentido, estas cifras podrían reducirse drásticamente si los hombres adoptaran los hábitos que las mujeres aceptaron hace muchos años: la de realizarse controles ginecológicos anualmente.
El Dr. Gonzalo Vitagliano, Jefe Sección Oncología y Urolaparoscopia del Hospital Alemán de Buenos Aires es uno de quienes aboga por un cambio en la manera de pensar. “Los hombres modernos tenemos que entender que debemos ir al urólogo de la misma manera en que las mujeres acuden al ginecólogo, es algo sencillo”; considera el especialista Universitario en Urología, Fellow en Urolaparoscopia y Magíster en Uro-oncología.

“Tenemos que cambiar la manera de pensar: los hombres estamos acostumbrados a solucionar el problema cuando ya está instalado. Por el contrario, la gimnasia mental que tenemos que realizar es que debemos anticiparnos, porque es mejor prevenir. Es algo que las mujeres han comprendido hace tiempo”, añade.
Cómo prevenir el cáncer de próstata y a qué edad realizar la primera consulta
Independientemente de la edad de la persona, para prevenir el cáncer de próstata de ninguna manera hay que esperar a sentir algún síntoma o indicio de que algo no está funcionando como debería.
Tampoco hay que conformarse con un chequeo clínico “porque hay pacientes que se quedan con un diagnóstico a medias, y suelen consultar con un urólogo cuando el problema ya se ha desatado”, considera el experto.
Vitagliano remarca que el primer control debe realizarse a los 50 años, pero esto es así cuando el varón no registra antecedentes de ningún tipo de cáncer en la familia.
“El especialista comienza haciendo un cuadro de situación, y si ve que el paciente tiene antecedentes familiares de enfermedad oncológica urológica o ginecológica, sugiere comenzar con el control a partir de los 45 años”, aclara.
Todavía más, cuando un familiar directo ha tenido cáncer de próstata a temprana edad, lo mejor es realizar la primera consulta a los 40 años. “Los pasos son muy sencillos –cuenta Vitagliano–. El urólogo pide una ecografía de riñón, vejiga y próstata, y una prueba de antígeno prostático, el famoso PSA. A partir de esos resultados, realizará los demás estudios pertinentes”.
La clave está en la detección temprana
Lo más importante, destacan los especialistas, es detectar los tumores en etapas curativas. “Los tumores de próstata en etapas más tempranas pueden ser curados. No obstante, cuando sale de la próstata, el tratamiento se enfocará en evitar la progresión mas que en lograr la curación”.
“Hace algo más de una década, el cáncer de próstata era sinónimo de diagnosticar y tratar sin hacer diferencias, pero hoy en día podemos seleccionar mucho mejor qué pacientes van a requerir de un tratamiento, de tal forma que ser diagnosticado no es sinónimo de ser tratado”, explica Vitagliano.
En este contexto, cuenta que varias de las consecuencias del tratamiento del cáncer de próstata han logrado ser minimizadas por las nuevas tecnologías.

“También en lo preventivo, la urología se ha visto revolucionada de la mano de la resonancia magnética nuclear de próstata y de los biomarcadores que han permitido no solo determinar la presencia del tumor en el estadio local, sino también poder pronosticar la agresividad del mismo mediante huellas genéticas”, subraya.
Por eso, reafirma, aunque ahora existen numerosos avances, como las terapias focales y las cirugías robóticas poco invasivas que han permitido tratar tumores de próstata minimizando el daño colateral; la mejor decisión sigue siendo anticiparse a esta etapa y realizar un chequeo temprano.
“El cáncer de próstata en sus etapas tempranas es completamente asintomático, por eso es necesario hacerse los controles periódicos para encontrarlo en su etapa curativa”, añade Vitagliano.
En definitiva, hay que cambiar el chip y adoptar las costumbres que ya han aceptado las mujeres desde hace muchos años. En vez de esperar a que aparezca el problema, podemos anticiparlo y prevenirlo con un simple control. Por eso la consulta temprana con el urólogo resulta fundamental.
________________________________________________________
Content LAB es la unidad de generación de ideas y contenidos de LA NACION para las marcas con distribución en sus plataformas digitales y redes sociales. Este contenido fue producido para un anunciante y publicado por el Content LAB. La redacción de LA NACION no estuvo involucrada en la generación de este contenido.
1Microbiota: el “oro líquido” que mejora la digestión y fue considerado el “té de la inmortalidad”
2Crianza: qué necesidades de los chicos hay que atender cuando van a la escuela
3Los riesgos de los hijos que se hacen cargo emocionalmente de sus padres
4Horóscopo: cómo será tu semana del 8 al 14 de marzo de 2026






